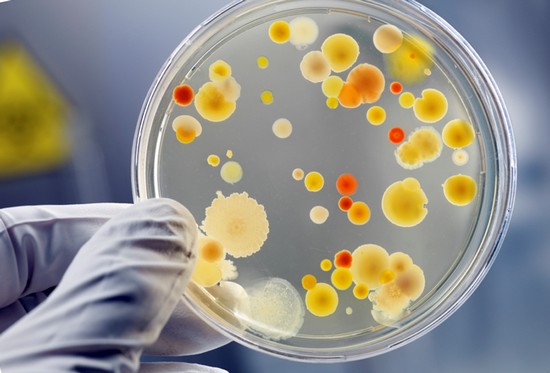

Болезни и лечение
Ядовитые соединения вызывают интоксикацию организма. Симптомы этого состояния не всегда такие, как принято считать. Человек, который отравился испарениями химикатов, жалуется на ощущения, не похожие на признаки пищевого отравления. В случае хронической интоксикации симптоматика насколько размыта, что порой трудно догадаться о ежедневном поступлении отравляющих веществ в организм. Давайте раскроем секреты коварных ядов!
Содержание
- 1 Операция «Рассекретим интоксикацию!»
- 2 Пищевое отравление
- 3 Интоксикация газами
- 4 Вредное воздействие химикатов
- 5 Хроническое отравление
- 6 Очищаем организм от «агрессоров»
Содержимое
Операция «Рассекретим интоксикацию!»
Интоксикация – это патологический процесс, в ходе которого органы и системы организма поражаются вследствие влияния токсических веществ. Провокаторы болезни проникают в организм разными путями:
- с продуктами питания, у которых истек срок годности;
- в результате превышения дозы лекарства;
- вследствие вдыхания отравляющего газа (угарного, бытового и т. д.);
- из-за случайного или намеренного употребления различных химических соединений, например, бытовой химии, кислот или щелочей, суррогатов алкоголя.

Отрава не всегда поступает внутрь извне. К выраженной интоксикации также приводят инфекционные заболевания, в том числе паразитарные, так как микробы и вирусы – источники токсинов, провоцирующих сильный воспалительный процесс. По этой причине больные часто ощущают недомогание.
На заметку. Интоксикация организма у ребенка начинается довольно быстро, потому что яд стремительно всасывается в кровь малыша. Проявления проблемы у детей такие же, как и у взрослых, но в большинстве случаев намного ярче.
Пищевое отравление
Если причиной интоксикации стала пища, в течение 6 часов после ее приема у больного возникают:
- болевые ощущения в области брюшины;
- метеоризм и кишечные колики;
- тошнота, приводящая к рвоте, которая приносит краткосрочное облегчение;
- диарея;
- учащение сердечного ритма;
- головная боль, головокружение и слабость;
- гипертермия (при кишечной инфекции).
Интоксикация газами

Вдыхание токсических газов дает о себе знать в течение трети часа. Чем больше опасного вещества в воздухе, тем быстрее человек почувствует, что:
- болит или кружится голова;
- глаза раздражены и слезятся;
- першит в горле;
- мучают приступы сухого кашля;
- стало тяжело дышать;
- возникла боль в области груди.
Кожа пострадавшего бледнеет, сердцебиение учащается, далее начинаются судороги. Без медицинской помощи он может впасть в кому и погибнуть.
Вредное воздействие химикатов
Когда в пищеварительную систему попадает кислота или щелочь, слизистые покровы ротовой полости, пищевода и желудка моментально обжигаются – пациент ощущает сильнейшую боль. Этот симптом сопровождается головной болью, тошнотой, диареей. Стенки органов пищеварения могут быть настолько поражены, что начинается внутреннее кровотечение. При отравлении аптечными препаратами к симптомам общего недомогания присоединяются признаки, указанные в инструкции препарата (разделы «Передозировка» и «Побочные действия»).
Хроническое отравление
Как ни удивительно, интоксикация может протекать в хронической форме, и не пару дней, а несколько лет. Чаще всего такой недуг выявляют у медиков, сотрудников производств, автозаправок, ведь они вынуждены ежедневно контактировать с вредными веществами. Хроническая интоксикация организма, разрушающая бронхи, легкие, поджелудочную железу, печень и другие жизненно важные органы, – постоянный спутник всех курильщиков.
Основные признаки этого состояния:

- ослабление иммунитета;
- постоянная усталость;
- плохая память;
- раздражительность;
- сбои в функционировании желудочно-кишечного тракта;
- потливость и нарушение терморегуляции;
- налет на языке и неприятный запах изо рта;
- высыпания на коже;
- аллергия;
- бессонница;
- ухудшение внешнего вида.
Очищаем организм от «агрессоров»
Чтобы ядовитые вещества не причинили значительного вреда здоровью, стоит запомнить, как вывести коварную интоксикацию из организма. Это возможно только тогда, когда кровь будет очищена от токсинов. Устранить последствия легкого пищевого отравления можно с помощью промывания желудка и приема сорбентов. Выбирайте препарат, который пригоден для длительного применения, так как придется принимать его около двух недель. Наиболее популярные и эффективные сорбенты – жидкий уголь, Полисорб, Смекта, Энтеросгель.
Перед тем как воспользоваться средством, внимательно прочитайте инструкцию по применению, особенно если вы собрались дать таблетку или суспензию ребенку.
Потребуется более длительное лечение, если симптомы интоксикации организма указывают на воздействие очень опасных веществ, например, при отравлении грибами, газами, химикатами или таблетками. В таком случае нужно немедленно вызвать скорую помощь. В больнице открываются более широкие возможности для удаления токсинов. Доктора «атакуют» их:

- антидотной и кислородной терапией;
- введением антитоксических сывороток;
- заместительной гемотрансфузией;
- переливанием кровезаменителей;
- гемодиализом, перитонеальным диализом и гемосорбцией;
- применением слабительных и мочегонных средств.
Несмотря на все достижения медицинской науки, симптомы интоксикации организма вернутся, если не изменить образ жизни. Конечно, в жизни бывают ситуации, когда приходится бороться с инфекцией, питаться фаст-фудом, позволить себе спиртное или жить в местности, где воздух очень загрязнен. Не ждите тогда, пока организм «пожалуется» вам на неудобства дискомфортными ощущениями – периодически принимайте безопасные сорбенты.
Читайте также:
- Какая диета поможет при увеличенной печени?
- Глисты у человека: симптомы, диагностика, лечение и профилактика
- Почему повышается или понижается гормон ГСПГ?
- Как очистить кровь от токсинов?
Отрава может поджидать человека везде: в еде, в воздухе, в коробочке с лекарством. Признаки поражения не всегда возникают сразу после попадания токсинов в организм – случается, до того, как человеку станет нехорошо, проходит немало времени. Умение быстро выявлять симптомы, характерные для различных видов интоксикации, может однажды спасти жизнь вам или кому-то другому.



